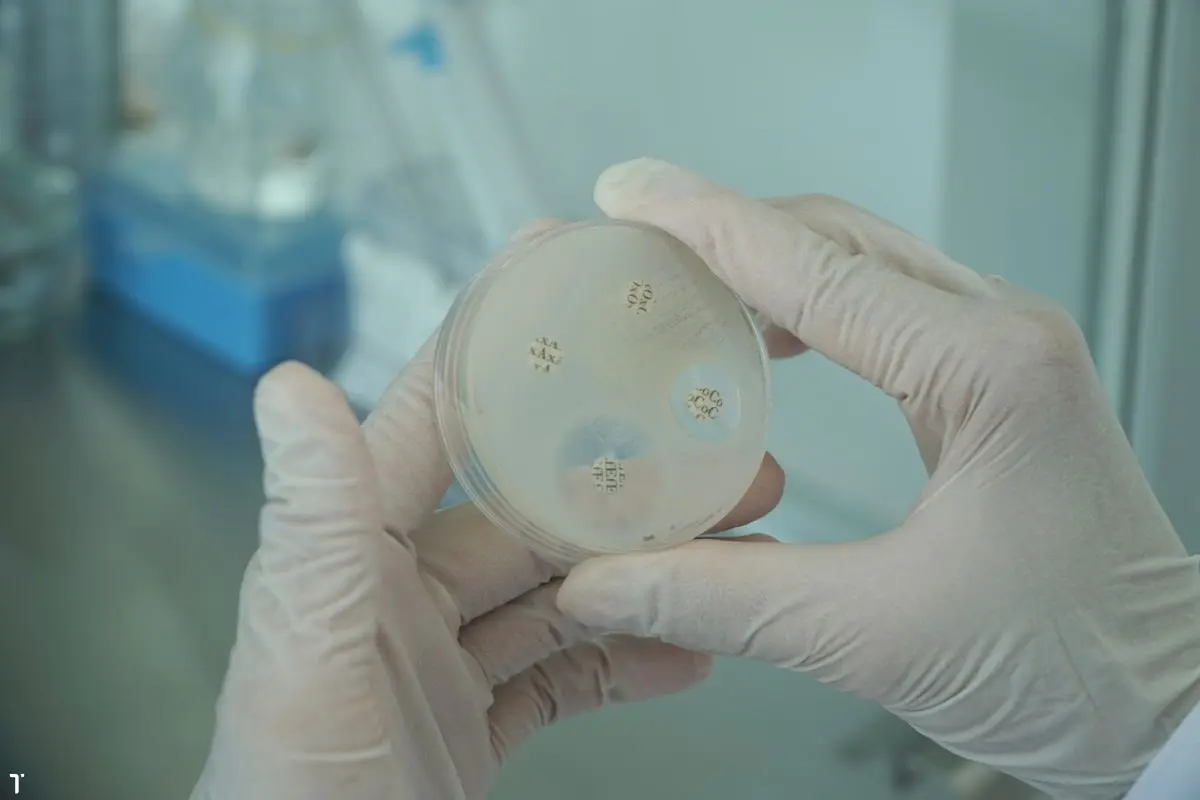
khang-sinh-do-2_1726716435

Trước nhu cầu ngày càng cao về các sản phẩm thủy sản trên toàn cầu, ngành nuôi trồng thủy sản đã phát triển mạnh mẽ. Tuy nhiên, sản xuất thâm canh đã mang lại những vấn đề về sức khỏe cho các loài thủy sản, dẫn đến việc sử dụng kháng sinh một cách không kiểm soát nhằm ngăn ngừa và điều trị bệnh.

Thực trạng này đã dẫn đến sự gia tăng ngày càng nghiêm trọng của tình trạng kháng thuốc kháng sinh (AMR), một vấn đề lớn đối với sức khỏe cộng đồng toàn cầu. Một nghiên cứu từ các nhà khoa học Đại học Södertörn (Thụy Điển), Đại học Leiden (Hà Lan), Đại học Stockholm (Thụy Điển) và Học viện Khoa học Hoàng gia Thụy Điển đã được công bố trên tạp chí Aquaculture International. Bài nghiên cứu mô tả cách thức các chiến lược giảm thiểu AMR đã phát triển trên bình diện quốc tế và tác động của chúng đến ngành nuôi trồng thủy sản (NTTS). Nhóm nghiên cứu cũng phân tích sự tuân thủ của các quốc gia và khu vực đối với các quy định và tiêu chuẩn kháng sinh được đưa ra bởi những chương trình chứng nhận chọn lọc.
Ngành NTTS ngày càng phát triển đã dẫn đến việc sử dụng kháng sinh ngày càng tăng để ngăn ngừa bệnh. Tuy nhiên, việc này đã gây ra những tác động tiêu cực nghiêm trọng. Kháng sinh thải ra môi trường có thể gây ô nhiễm nước, đất và trầm tích, dẫn đến sự phát triển của vi khuẩn kháng thuốc, có thể lây truyền sang các loài khác, bao gồm cả con người. Để giải quyết vấn đề này, cách tiếp cận One Health – Một Sức Khỏe được đề xuất. Khái niệm này nhận thức rằng sức khỏe con người, động vật, thực vật và môi trường đều có mối liên hệ chặt chẽ với nhau và yêu cầu một cách tiếp cận liên ngành để đạt hiệu quả tốt nhất trong việc chống lại AMR.
Khung Pháp Lý Hiện Hành Chưa Đủ Mạnh
Các tổ chức quốc tế như FAO và WHO đã nhấn mạnh tầm quan trọng của việc giải quyết AMR trong NTTS. Dù đã có những hướng dẫn và khuyến nghị để giảm thiểu việc sử dụng kháng sinh và ngăn ngừa vi khuẩn kháng thuốc, việc thực hiện vẫn khác biệt lớn giữa các quốc gia. Một số quốc gia đã có các biện pháp nghiêm ngặt, trong khi đó, có nơi lại thiếu khung pháp lý đủ mạnh. Điều này dẫn đến những thách thức cho thương mại quốc tế và duy trì tình trạng kháng thuốc. Phân tích khoa học từ các nghiên cứu cho thấy còn thiếu sự phối hợp cụ thể trong NTTS trong cuộc chiến chống lại AMR. Hơn nữa, nhiều chương trình chứng nhận bền vững chưa đặt ra những tiêu chuẩn rõ ràng hoặc đủ mạnh về việc sử dụng kháng sinh.
Tác Động Kinh Tế của AMR Trong NTTS
Việc thiếu biện pháp kiểm soát kháng sinh trong NTTS có hậu quả kinh tế lớn. Các quốc gia có quy định lỏng lẻo có thể bị hạn chế thương mại và thiệt hại nghiêm trọng khi phát hiện dư lượng kháng sinh trong sản phẩm của họ. Ngược lại, đầu tư vào các hoạt động bền vững và tuân thủ các tiêu chuẩn quốc tế có thể tăng lợi ích dài hạn bằng cách cải thiện hình ảnh ngành và tiếp cận các thị trường khó tính hơn.
 Kháng sinh đồ hỗ trợ người nuôi biết rõ loại kháng sinh bị kháng. Ảnh: hoachatbamien.com
Kháng sinh đồ hỗ trợ người nuôi biết rõ loại kháng sinh bị kháng. Ảnh: hoachatbamien.com
Thách Thức Trong Việc Thực Hiện Các Quy Định Quốc Gia
Nghiên cứu chỉ ra rằng nhiều quốc gia chưa thực hiện đầy đủ các khuyến nghị quốc tế về kháng sinh trong NTTS. Sự cho phép sử dụng kháng sinh ưu tiên cao gây tổn hại đến sức khỏe động vật, môi trường và cộng đồng. Việc sử dụng kháng sinh bừa bãi trong NTTS không chỉ gây tổn hại đến động vật thủy sản mà còn thải kháng sinh ra môi trường, dẫn đến vi khuẩn kháng thuốc. Điều này có thể ảnh hưởng trực tiếp đến sức khỏe con người.
Các Hành Động Cần Thiết
Đối phó với AMR trong NTTS cần có các biện pháp mạnh mẽ và kịp thời. Điều này bao gồm việc phát triển và thực hiện các quy định khắt khe hơn, đặc biệt là những quy định cơ bản. Ngành NTTS cần áp dụng các chiến lược giảm thiểu sử dụng kháng sinh như tăng cường an toàn sinh học, phát triển vắc-xin, sử dụng men vi sinh và prebiotic, tối ưu hóa điều kiện nuôi. Nghiên cứu và phát triển các loại thuốc kháng khuẩn mới và thay thế cũng là cần thiết. Người tiêu dùng cũng có vai trò quan trọng trong việc lựa chọn sản phẩm từ NTTS bền vững, khuyến khích sản xuất có trách nhiệm.
AMR đang là một nguy cơ lớn đối với cả NTTS và sức khỏe toàn cầu. Việc tăng cường quy định và thúc đẩy sử dụng kháng sinh có trách nhiệm là hết sức cần thiết. Các kết luận chính gồm có:
Các cam kết quốc tế đã tác động tích cực đến quy định quốc gia về kháng sinh trong NTTS, nhưng vẫn cần hoàn thiện. Quy định cần nghiêm ngặt hơn, đặc biệt là với kháng sinh dự phòng và tần suất sử dụng. Quản lý sức khỏe động vật tốt hơn có thể giảm việc sử dụng kháng sinh, và biện pháp quản lý trang trại phù hợp có thể giảm thiểu sử dụng kháng sinh đáng kể.
Sử dụng đúng loại kháng sinh để tránh mất chi phí và điều trị không hiệu quả. Ảnh: hoachatbamien.com
Sử dụng đúng loại kháng sinh để tránh mất chi phí và điều trị không hiệu quả. Ảnh: hoachatbamien.com
Quản lý sức khỏe động vật tốt hơn có thể làm giảm đáng kể việc sử dụng kháng sinh. Điều này bao gồm cải thiện chất lượng nước, giảm căng thẳng cho động vật và cung cấp chế độ ăn bổ sung. Các biện pháp quản lý trang trại phù hợp có thể giảm thiểu việc sử dụng kháng sinh xuống còn ba lần hoặc ít hơn mỗi chu kỳ sản xuất.
Nghiên cứu cho thấy tiến bộ trong việc giảm sử dụng kháng sinh trong NTTS, nhưng còn nhiều việc phải làm. Bằng cách hợp tác cải thiện quy định và thực hiện các biện pháp tốt nhất, chúng ta có thể đảm bảo một tương lai bền vững cho NTTS. Ngành NTTS cần tiên phong tìm các giải pháp mới để chống lại AMR và đảm bảo thực phẩm thủy sản an toàn, trách nhiệm.
